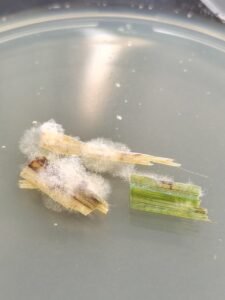
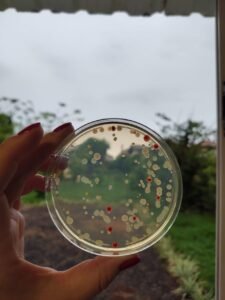
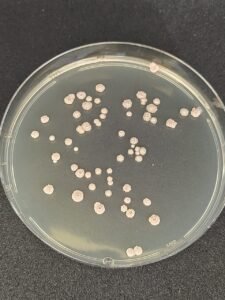

Não perca nenhum LANCE!
Faça parte da nossa comunidade! E receba antes o que é notícia em promeira mão.
Desde 2015, informamos com imparcialidade, lutamos contra a desinformação e fortalecemos a comunidade. Nosso lance é você!
Confira os portais que fazem parte do Lance Notícias:
27/03/26 - às 15:04
Compartilhe:
A aplicação da microbiologia na agricultura tem ganhado espaço como alternativa para aumentar a produtividade de forma sustentável. A área, conhecida como microbiologia agrícola, estuda microrganismos como bactérias, fungos e vírus que interagem com o solo, as plantas e os animais, influenciando diretamente processos essenciais como a ciclagem de nutrientes, a fertilidade do solo e o controle de pragas e doenças.
Os microrganismos, invisíveis a olho nu por possuírem dimensões que variam entre micrômetros e nanômetros, estão presentes em praticamente todos os ambientes do planeta, inclusive em condições extremas. Na agricultura, esses organismos desempenham funções estratégicas, podendo atuar tanto de forma benéfica quanto prejudicial, dependendo da sua interação com o sistema produtivo.
Dentro desse contexto, a microbiologia agrícola engloba áreas como a fitopatologia, que investiga doenças em plantas causadas por diferentes agentes, incluindo fungos, bactérias, vírus e nematoides. A identificação correta desses patógenos, por meio de análises laboratoriais e técnicas de isolamento em meios de cultura, é considerada fundamental para orientar decisões de manejo no campo.
Com a crescente demanda por práticas agrícolas mais sustentáveis, os produtos biológicos têm se consolidado como uma alternativa aos insumos químicos tradicionais. Esses produtos são desenvolvidos a partir de microrganismos, extratos naturais, enzimas ou metabólitos, e são utilizados para promover o crescimento das plantas, melhorar a absorção de nutrientes e auxiliar no controle biológico de pragas e doenças.
De acordo com a engenheira de bioprocessos e biotecnologia Melissa Remlinger, mestre em biotecnologia e proprietária da MRBiotecnologica, parceira da Agratec, o uso de microrganismos na agricultura representa um avanço importante na busca por sistemas produtivos mais equilibrados. A Agratec atua no desenvolvimento de soluções voltadas ao aumento da produtividade no campo, com foco em tecnologias integradas.
Entre os biológicos mais utilizados estão os produtos à base de bactérias e fungos, escolhidos conforme sua função específica, como a promoção do crescimento vegetal, a solubilização de nutrientes como fósforo, potássio e nitrogênio e o controle de pragas, incluindo insetos e nematoides. Esses insumos costumam apresentar menor toxicidade em comparação aos agroquímicos convencionais, além de contribuírem para a preservação de organismos benéficos no ambiente agrícola.
Os produtos biológicos podem ser adquiridos comercialmente ou produzidos diretamente nas propriedades rurais, no modelo conhecido como “on farm”. No entanto, a legislação brasileira, por meio da Lei nº 15.070, de 23 de dezembro de 2024, estabelece que esses produtos não podem ser comercializados quando multiplicados na própria fazenda, sendo permitidos apenas para uso próprio ou em sistemas coletivos, como associações e cooperativas.
Especialistas destacam que a eficácia dos bioinsumos depende da qualidade do material utilizado. Fatores como a presença de cepas eficientes, a concentração adequada de microrganismos viáveis e a ausência de contaminantes são determinantes para os resultados no campo. Por isso, análises laboratoriais são recomendadas para garantir a segurança e a eficiência desses produtos.
Nesse cenário, a microbiologia aplicada à agricultura se consolida como uma área estratégica, aliando conhecimento científico e inovação tecnológica para atender às demandas de produtividade e sustentabilidade no setor agrícola.

